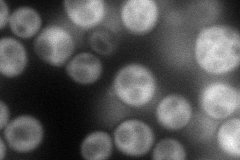
YPR032W
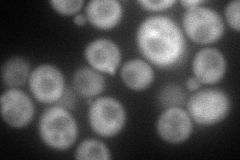
YPR032W
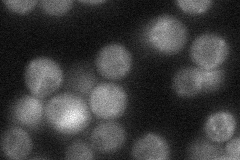
YPR032W
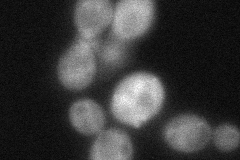
YPR032W
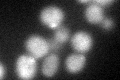
YPR032W
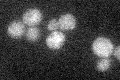
YPR032W

View description
Effector of Rab GTPase Sec4p, forms a complex with Sec4p and t-SNARE Sec9p; involved in exocytosis and docking and fusion of post-Golgi vesicles with plasma membrane; homolog of Sro77p and Drosophila lgl tumor suppressor
Localization:
Intensity:
Fold change:
Significance:
-
C’ GFP library in SD

bud neckN/A -
N' NOP1pr-GFP in SD
cytosol106.447 -
N' TEF2pr-mCherry in SD
cytosol,bud112.291 -
N' NATIVEpr-GFP in SD
punctate,bud neck33.1468 -
N' TEF2pr-VC and Cyto-VN in SD
cytosol56.0803 -
C’ GFP library in SD+DTT
bud neck24.630.84No -
C’ GFP library in SD+H2O2

bud neck24.630.84No -
C’ GFP library in Starvation Media
bud neck27.990.95No -
C’ GFP library on the background of Pup2-DaMP

bud neck -
C’ GFP library on the background of CCT mutant

bud neck21.53470.734852No
